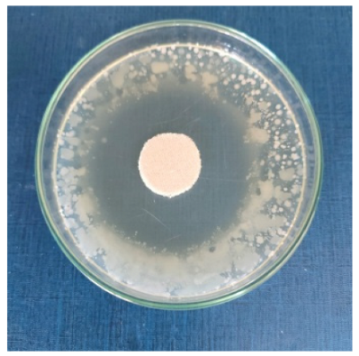
Biomimetics 10 00737 i007 Biomimetics 10 00737 i007
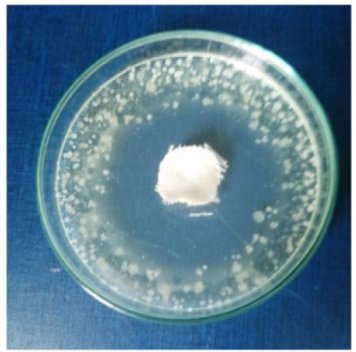
Biomimetics 10 00737 i008 Biomimetics 10 00737 i008

Antimicrobial Efficacy of Green Silver Nanoparticles Synthesized Using Crataegus monogyna Extract
Abstract
1. Introduction
2. Materials and Methods
2.1. Materials
2.2. Synthesis and Characterization of Green Silver Nanoparticles
2.2.1. Synthesis and Optimization Strategies of AgNPs
2.2.2. The Physico-Chemical and Morphological Characterization of Silver Nanoparticles
2.2.3. The In Vitro Evaluation of Antioxidant Activity
2.2.4. Polyphenol Determination for Entrapment Efficiency
2.3. Textiles Treatment and Characterization
2.4. Statistical Analysis
3. Results and Discussion
3.1. Compositional Characterization of Crataegus Monogyna Extract by FT-ICR MS
3.2. UV-VIS Spectral Characterization of AgNPs Dispersions
3.3. Dimensional and Physical Stability Evaluation of Nanoparticles
3.4. Determination of Antioxidant Potential and Phenolic Content
3.5. Morphology and Crystallinity Characterization of AgNPs Obtained with Crataegus Monogyna Extract
3.6. Morphology of Textile Fibres Treated with AgNPs Dispersion Based on Crataegus Monogyna Extract
3.7. Studying the Impact of AgNP Dispersions Synthesized Based on Crataegus Monogyna Extract on Textile Samples by Monitoring Chromatic Parameters
3.8. Evaluation of Antimicrobial Activity
4. Conclusions
Supplementary Materials
Author Contributions
Funding
Institutional Review Board Statement
Informed Consent Statement
Data Availability Statement
Conflicts of Interest
References
- Mollick, S.; Repon, R.; Haji, A.; Jalil, M.A.; Islam, T.; Khan, M.M. Progress in Self-Cleaning Textiles: Parameters, Mechanism and Applications. Cellulose 2023, 30, 10633–10680. [Google Scholar] [CrossRef]
- Libanori, A.; Chen, G.; Zhao, X.; Zhou, Y.; Chen, J. Smart Textiles for Personalized Healthcare. Nat. Electron. 2022, 5, 142–156. [Google Scholar] [CrossRef]
- Chirila, L.; Popescu, A.; Ignat, M.; Avadanei, M.; Lite, C.M. Development of Antimicrobial Hydrogels for Burn Wound Treatment. Ind. Textila 2024, 75, 194–202. [Google Scholar] [CrossRef]
- Ghosh, J.; Rupanty, N.S.; Noor, T.; Asif, T.R.; Islam, T.; Reukov, V. Functional Coatings for Textiles: Advancements in Flame Resistance, Antimicrobial Defense, and Self-Cleaning Performance. RSC Adv. 2025, 15, 10984–11022. [Google Scholar] [CrossRef] [PubMed]
- Li, D.; Feng, S.; Tao, J.; Yu, S.; He, Y.; Yu, R.; Xiang, H.; Wang, C.; Zhu, M. Optimizing Sustainability in Textile Recycling: Life Cycle Assessment of Recycled Polyester Staple Fibers with a Focus on Carbon Emissions, Energy Efficiency, and Water Conservation. ACS Sustain. Chem. Eng. 2024, 12, 17347–17356. [Google Scholar] [CrossRef]
- Zhang, R.; Lin, H.; Wang, Z.; Cheng, S.; Li, C.; Wang, Y. Research Progress on Antimicrobial Biomaterials. Macromol. Biosci. 2025, 25, e00239. [Google Scholar] [CrossRef]
- Mirmohammadsadeghi, S.; Juhas, D.; Parker, M.; Peranidze, K.; Van Horn, D.A.; Sharma, A.; Patel, D.; Sysoeva, T.A.; Klepov, V.; Reukov, V. The Highly Durable Antibacterial Gel-like Coatings for Textiles. Gels 2024, 10, 398. [Google Scholar] [CrossRef]
- Tarannum, N.; Pooja, K.; Singh, A.; Jain, P.; Raghav, S.; Lahari, V. The Evolution of Antimicrobial Fabrics: Nanoparticles as Key Agents in Textiles Innovation. J. Ind. Text. 2025, 55, 1. [Google Scholar] [CrossRef]
- Periolatto, M.; Ferrero, F.; Vineis, C.; Varesano, A.; Gozzelino, G. Novel Antimicrobial Agents and Processes for Textile Applications. In Antibacterial Agents; IntechOpen: Pondicherry, India, 2017. [Google Scholar] [CrossRef]
- Staneva, D.; Atanasova, D.; Angelova, D.; Grozdanov, P.; Nikolova, I.; Grabchev, I. Antimicrobial Properties of Chitosan-Modified Cotton Fabric Treated with Aldehydes and Zinc Oxide Particles. Materials 2023, 16, 5090. [Google Scholar] [CrossRef]
- Kumari, B.; Arya, N.; Neeta; Verma, P. Antimicrobial Textiles: Innovations, Challenges and Applications for Health and Hygiene. Asian J. Res. Biochem. 2025, 15, 13–36. [Google Scholar] [CrossRef]
- Granados, A.; Pleixats, R.; Vallribera, A. Recent Advances on Antimicrobial and Anti-Inflammatory Cotton Fabrics Containing Nanostructures. Molecules 2021, 26, 3008. [Google Scholar] [CrossRef]
- Sahin, F.; Celik, N.; Ceylan, A.; Ruzi, M.; Onses, M.S. One-Step Green Fabrication of Antimicrobial Surfaces via In Situ Growth of Copper Oxide Nanoparticles. ACS Omega 2022, 7, 26504–26513. [Google Scholar] [CrossRef]
- Chen, H.-T.; Huang, M.-C.; Chiang, Y.-Y.; Chang, Y.; Wu, C.-C. Industrially Compatible Manufacturing Process of Wash-Durable Antimicrobial Textiles Using Cuprous Oxide–Polymer Composites. Mater. Adv. 2025, 6, 2507–2520. [Google Scholar] [CrossRef]
- Giedraitienė, A.; Ružauskas, M.; Šiugždinienė, R.; Tučkutė, S.; Grigonis, K.; Milčius, D. ZnO Nanoparticles Enhance the Antimicrobial Properties of Two-Sided-Coated Cotton Textile. Nanomaterials 2024, 14, 1264. [Google Scholar] [CrossRef] [PubMed]
- Nawab, R.; Iqbal, A.; Niazi, F.; Iqbal, G.; Khurshid, A.; Saleem, A.; Munis, M.F.H. Review Featuring the Use of Inorganic Nano-Structured Material for Anti-Microbial Properties in Textile. Polym. Bull. 2023, 80, 7221–7245. [Google Scholar] [CrossRef]
- Veselova, V.O.; Plyuta, V.A.; Kostrov, A.N.; Vtyurina, D.N.; Abramov, V.O.; Abramova, A.V.; Voitov, Y.I.; Padiy, D.A.; Thu, V.T.H.; Hue, L.T.; et al. Long-Term Antimicrobial Performance of Textiles Coated with ZnO and TiO2 Nanoparticles in a Tropical Climate. J. Funct. Biomater. 2022, 13, 233. [Google Scholar] [CrossRef]
- Giedraitienė, A.; Ružauskas, M.; Šiugždinienė, R.; Tučkutė, S.; Grigonis, K.; Milčius, D. Development of Antibacterial Cotton Textiles by Deposition of Fe2O3 Nanoparticles Using Low-Temperature Plasma Sputtering. Nanomaterials 2023, 13, 3106. [Google Scholar] [CrossRef]
- Wu, J.; Yue, X.; Wang, T.; Zhang, Y.; Jin, Y.; Li, G. A Cost-Effective and Sensitive Voltammetric Sensor for Determination of Baicalein in Herbal Medicine Based on Shuttle-Shape α-Fe2O3 Nanoparticle Decorated Multi-Walled Carbon Nanotubes. Colloids Surf. A Physicochem. Eng. Asp. 2025, 717, 136850. [Google Scholar] [CrossRef]
- Yılmaz, G.E.; Göktürk, I.; Ovezova, M.; Yılmaz, F.; Kılıç, S.; Denizli, A. Antimicrobial Nanomaterials: A Review. Hygiene 2023, 3, 269–290. [Google Scholar] [CrossRef]
- Wang, H.; Jin, C.; Li, X.; Ma, J.-X.; Ye, Y.-F.; Tang, L.-X.; Si, J.; Cui, B.-K. A Green Biocatalyst Fabricated by Fungal Laccase Immobilized onto Fe3O4@polyaniline-Chitosan Nanofibrous Composites for the Removal of Phenolic Compounds. Chem. Eng. J. 2025, 507, 160486. [Google Scholar] [CrossRef]
- Veg, E.; Hashmi, K.; Raza, S.; Joshi, S.; Rahman Khan, A.; Khan, T. The Role of Nanomaterials in Diagnosis and Targeted Drug Delivery. Chem. Biodivers. 2025, 22, e202401581. [Google Scholar] [CrossRef]
- Lite, M.-C.; Săndulache, I.-M.; Tănăsescu, E.-C.; Constantinescu, R.; Ungureanu, C.; Badea, N. Silver nanoparticles based on caffeic acid applied for textiles preservation. UPB Sci. Bull. Ser. B Chem. Mater. Sci. 2023, 85, 1–12. [Google Scholar]
- Besliu, D.-V.; Meghea, A. Optimization of green synthesis of silver nanoparticles by using harpagophytum procumbens root extract. UPB Sci. Bull. Ser. B Chem. Mater. Sci. 2021, 83, 19–28. [Google Scholar]
- Zhao, Y.; Zhao, K.; Jiang, K.; Tao, S.; Li, Y.; Chen, W.; Kou, S.; Gu, C.; Li, Z.; Guo, L.; et al. A Review of Flavonoids from Cassia Species and Their Biological Activity. Curr. Pharm. Biotechnol. 2016, 17, 1134–1146. [Google Scholar] [CrossRef]
- Esther Arland, S.; Kumar, J. Green and Chemical Syntheses of Silver Nanoparticles: Comparative and Comprehensive Study on Characterization, Therapeutic Potential, and Cytotoxicity. Eur. J. Med. Chem. Rep. 2024, 11, 100168. [Google Scholar] [CrossRef]
- Mousavi-Khattat, M.; Keyhanfar, M.; Razmjou, A. A Comparative Study of Stability, Antioxidant, DNA Cleavage and Antibacterial Activities of Green and Chemically Synthesized Silver Nanoparticles. Artif. Cells Nanomed. Biotechnol. 2018, 46, 1022–1031. [Google Scholar] [CrossRef] [PubMed]
- dos Santos, O.A.L.; de Araujo, I.; Dias da Silva, F.; Sales, M.N.; Christoffolete, M.A.; Backx, B.P. Surface Modification of Textiles by Green Nanotechnology against Pathogenic Microorganisms. Curr. Res. Green Sustain. Chem. 2021, 4, 100206. [Google Scholar] [CrossRef]
- Balamurugan, M.; Saravanan, S.; Soga, T. Coating of Green-Synthesised Silver Nanoparticles on Cotton Fabric. J. Coat. Technol. Res. 2017, 14, 735–745. [Google Scholar] [CrossRef]
- Aabdelghaffar, F.; Mahmoud, M.G.; Asker, M.S.; Mohamed, S.S. Facile Green Silver Nanoparticles Synthesis to Promote the Antibacterial Activity of Cellulosic Fabric. J. Ind. Eng. Chem. 2021, 99, 224–234. [Google Scholar] [CrossRef]
- Antunes Filho, S.; Almeida, C.M.; Romanos, M.T.V.; Pizzorno Backx, B.; Regina Bonelli, R. Green Synthesis of Silver Nanoparticles for Functional Cotton Fabrics: Antimicrobial Efficacy against Multidrug-Resistant Bacteria and Cytotoxicity Evaluation. Artif. Cells Nanomed. Biotechnol. 2025, 53, 153–165. [Google Scholar] [CrossRef]
- Ghiniwa, A.I.; Zahran, M.K.; El Rafie, H.; Ayad, E.; Abdelaziz, M.; Mohamed, T.S. Phytochemical-Assisted Green Synthesis of Antioxidant and Antimicrobial Silver Nanoparticles Using Cichorium intybus Extract for Enhanced Medical Cotton Fabrics. Egypt. J. Chem. 2025, 68, 715–728. [Google Scholar] [CrossRef]
- Ahmed, T.; Sezgin Bozok, S.; Ogulata, R.T. Comparison of in Situ and Padding Method to Incorporate Green Synthesized AgNPs by Using Calendula arvensis into Nonwoven Fabrics. J. Adhes. Sci. Technol. 2024, 38, 2047–2064. [Google Scholar] [CrossRef]
- Nguyen, T.-A.-M.; Phan, H.-V.-T.; Thao, V.-T.-M.; Nguyen, M.-K.; Dang, T.T.; Do, N.-T.; Dang, L.-T.-C.; Huynh, T.-M.-S.; Dao, M.-T.; Nguyen, V.-K.; et al. Green in Situ Fabrication of Silver Nanoparticles Coated Silk Using Aqueous Leaf Extract of Premna serratifolia (L.) for Antibacterial Textiles. Surf. Interfaces 2025, 72, 106976. [Google Scholar] [CrossRef]
- Jain, A.; Kongkham, B.; Puttaswamy, H.; Butola, B.S.; Malik, H.K.; Malik, A. Development of Wash-Durable Antimicrobial Cotton Fabrics by In Situ Green Synthesis of Silver Nanoparticles and Investigation of Their Antimicrobial Efficacy against Drug-Resistant Bacteria. Antibiotics 2022, 11, 864. [Google Scholar] [CrossRef]
- Ilieș, A.; Hodor, N.; Pantea, E.; Ilieș, D.C.; Indrie, L.; Zdrîncă, M.; Iancu, S.; Caciora, T.; Chiriac, A.; Ghergheles, C.; et al. Antibacterial Effect of Eco-Friendly Silver Nanoparticles and Traditional Techniques on Aged Heritage Textile, Investigated by Dark-Field Microscopy. Coatings 2022, 12, 1688. [Google Scholar] [CrossRef]
- Liu, H.; Lv, M.; Deng, B.; Li, J.; Yu, M.; Huang, Q.; Fan, C. Laundering Durable Antibacterial Cotton Fabrics Grafted with Pomegranate-Shaped Polymer Wrapped in Silver Nanoparticle Aggregations. Sci. Rep. 2014, 4, 5920. [Google Scholar] [CrossRef]
- Tahir, I.; Amina, S.J.; Ahmad, N.M.; Janjua, H.A. Antimicrobial Coating of Biologically Synthesized Silver Nanoparticles on Surgical Fabric and Surgical Blade to Prevent Nosocomial Infections. Heliyon 2024, 10, e35968. [Google Scholar] [CrossRef]
- Dai, Y.; Li, H.; Wan, J.; Liang, L.; Yan, J. Green In-Situ Synthesis of Silver Nanoparticles from Natural Madder Dye for the Preparation of Coloured Functional Cotton Fabric. Ind. Crops Prod. 2024, 208, 117871. [Google Scholar] [CrossRef]
- Ohi, K.A.M.; Banna, B.U.; Ahmed, T.; Al Reza, M.; Muktadir, A.; Hassan, M.M.; Arnob, A.K.; Assiri, M.A.; Mia, R. Green Synthesized AgNPs Induced Natural Dyeing of Cotton-Viscose Blended Fabric to Produce Functional Textile. Results Eng. 2025, 27, 106308. [Google Scholar] [CrossRef]
- Rehan, M.; Ibrahim, G.E.; Mashaly, H.M.; Hasanin, M.; Rashad, H.G.; Mowafi, S. Simultaneous Dyeing and Multifunctional Finishing of Natural Fabrics with Hibiscus Flowers Extract. J. Clean. Prod. 2022, 374, 133992. [Google Scholar] [CrossRef]
- Bardakci, H.; Celep, E.; Gözet, T.; Kan, Y.; Kırmızıbekmez, H. Phytochemical Characterization and Antioxidant Activities of the Fruit Extracts of Several Crataegus Taxa. S. Afr. J. Bot. 2019, 124, 5–13. [Google Scholar] [CrossRef]
- Shirzadi-Ahodashti, M.; Mortazavi-Derazkola, S.; Ebrahimzadeh, M.A. Biosynthesis of Noble Metal Nanoparticles Using Crataegus Monogyna Leaf Extract (CML@X-NPs, X= Ag, Au): Antibacterial and Cytotoxic Activities against Breast and Gastric Cancer Cell Lines. Surf. Interfaces 2020, 21, 100697. [Google Scholar] [CrossRef]
- Mehmood, A.; Zahir, S.; Khan, M.A.R.; Ahmad, K.S.; Abasi, F.; Raffi, M.; Proćków, J.; de la Lastra, J.M.P. Optimization and Bio-Fabrication of Phyto-Mediated Silver Nanoparticles (Ag-NPs) for Antibacterial Potential. J. Biomol. Struct. Dyn. 2024, 42, 8063–8072. [Google Scholar] [CrossRef] [PubMed]
- Smitha, S.L.; Nissamudeen, K.M.; Philip, D.; Gopchandran, K.G. Studies on Surface Plasmon Resonance and Photoluminescence of Silver Nanoparticles. Spectrochim. Acta A Mol. Biomol. Spectrosc. 2008, 71, 186–190. [Google Scholar] [CrossRef]
- Lacatusu, I.; Badea, N.; Badea, G.; Brasoveanu, L.; Stan, R.; Ott, C.; Oprea, O.; Meghea, A. Ivy Leaves Extract Based—Lipid Nanocarriers and Their Bioefficacy on Antioxidant and Antitumor Activities. RSC Adv. 2016, 6, 77243–77255. [Google Scholar] [CrossRef]
- ISO 14502-1:2005; Determination of Substances Characteristic of Green and Black Tea, Part 1: Content of Total Polyphe nols in Tea—Colorimetric Method Using Folin-Ciocalteu Reagent. International Organization for Standardization: Geneva, Switzerland, 2005.
- Wilfred, I. Society of Dyers and Colourists. In Colour for Textiles: A User’s Handbook; Society of Dyers and Colourists: Bradford, UK, 1993; ISBN 0901956562. [Google Scholar]
- ISO20743:2007; Textiles-Determination of Antibacterial Activity of Antibacterial Finished Products. International Organization for Standardization: Geneva, Switzerland, 2007.
- Valgas, C.; De Souza, S.M.; Smânia, E.F.A.; Smânia, A., Jr. Screening Methods to Determine Antibacterial Activity of Natural Products. Braz. J. Microbiol. 2007, 38, 369–380. [Google Scholar] [CrossRef]
- Barbinta-Patrascu, M.E.; Ungureanu, C.; Iordache, S.M.; Iordache, A.M.; Bunghez, I.-R.; Ghiurea, M.; Badea, N.; Fierascu, R.-C.; Stamatin, I. Eco-Designed Biohybrids Based on Liposomes, Mint–Nanosilver and Carbon Nanotubes for Antioxidant and Antimicrobial Coating. Mater. Sci. Eng. C 2014, 39, 177–185. [Google Scholar] [CrossRef]
- María Ruiz-Rodríguez, B.; de Ancos, B.; Sánchez-Moreno, C.; Fernández-Ruiz, V.; de Cortes Sánchez-Mata, M.; Cámara, M.; Tardío, J. Wild Blackthorn (Prunus spinosa L.) and Hawthorn (Crataegus monogyna Jacq.) Fruits as Valuable Sources of Antioxidants. Fruits 2014, 69, 61–73. [Google Scholar] [CrossRef]
- Cosmulescu, S.; Trandafir, I.; Nour, V. Phenolic Acids and Flavonoids Profiles of Extracts from Edible Wild Fruits and Their Antioxidant Properties. Int. J. Food Prop. 2017, 20, 3124–3134. [Google Scholar] [CrossRef]
- Htwe, Y.Z.N.; Chow, W.S.; Suda, Y.; Mariatti, M. Effect of Silver Nitrate Concentration on the Production of Silver Nanoparticles by Green Method. Mater. Today Proc. 2019, 17, 568–573. [Google Scholar] [CrossRef]
- Lite, M.C.; Constantinescu, R.R.; Tănăsescu, E.C.; Kuncser, A.; Romanițan, C.; Lăcătuşu, I.; Badea, N. Design of Green Silver Nanoparticles Based on Primula Officinalis Extract for Textile Preservation. Materials 2022, 15, 7695. [Google Scholar] [CrossRef]
- Nadzir, M.M.; Idris, F.N.; Hat, K. Green Synthesis of Silver Nanoparticle Using Gynura procumbens Aqueous Extracts. AIP Conf. Proc. 2019, 2124, 030018. [Google Scholar] [CrossRef]
- Tanase, C.; Berta, L.; Mare, A.; Man, A.; Talmaciu, A.I.; Roșca, I.; Mircia, E.; Volf, I.; Popa, V.I. Biosynthesis of Silver Nanoparticles Using Aqueous Bark Extract of Picea Abies L. and Their Antibacterial Activity. Eur. J. Wood Wood Prod. 2020, 78, 281–291. [Google Scholar] [CrossRef]
- Ali, M.; Kim, B.; Belfield, K.D.; Norman, D.; Brennan, M.; Ali, G.S. Green Synthesis and Characterization of Silver Nanoparticles Using Artemisia Absinthium Aqueous Extract—A Comprehensive Study. Mater. Sci. Eng. C 2016, 58, 359–365. [Google Scholar] [CrossRef] [PubMed]
- Ryu, S.; Nam, S.-H.; Baek, J.-S. Green Synthesis of Silver Nanoparticles (AgNPs) of Angelica Gigas Fabricated by Hot-Melt Extrusion Technology for Enhanced Antifungal Effects. Materials 2022, 15, 7231. [Google Scholar] [CrossRef] [PubMed]
- Wei, S.; Hao, M.; Tang, Z.; Zhou, T.; Zhao, F.; Wang, Y. Non-Medicinal Parts of Safflower (Bud and Stem) Mediated Sustainable Green Synthesis of Silver Nanoparticles under Ultrasonication: Optimization, Characterization, Antioxidant, Antibacterial and Anticancer Potential. RSC Adv. 2022, 12, 36115–36125. [Google Scholar] [CrossRef] [PubMed]
- Aghajani Kalaki, Z.; SafaeiJavan, R.; Faraji, H. Procedure Optimisation for Green Synthesis of Silver Nanoparticles by Taguchi Method. Micro Nano Lett. 2018, 13, 558–561. [Google Scholar] [CrossRef]
- Rolim, W.R.; Pelegrino, M.T.; de Araújo Lima, B.; Ferraz, L.S.; Costa, F.N.; Bernardes, J.S.; Rodigues, T.; Brocchi, M.; Seabra, A.B. Green Tea Extract Mediated Biogenic Synthesis of Silver Nanoparticles: Characterization, Cytotoxicity Evaluation and Antibacterial Activity. Appl. Surf. Sci. 2019, 463, 66–74. [Google Scholar] [CrossRef]
- Ajitha, B.; Ashok Kumar Reddy, Y.; Sreedhara Reddy, P. Green Synthesis and Characterization of Silver Nanoparticles Using Lantana Camara Leaf Extract. Mater. Sci. Eng. C 2015, 49, 373–381. [Google Scholar] [CrossRef]
- Ibrahim, H.M.; Zaghloul, S.; Hashem, M.; El-Shafei, A. A Green Approach to Improve the Antibacterial Properties of Cellulose Based Fabrics Using Moringa Oleifera Extract in Presence of Silver Nanoparticles. Cellulose 2021, 28, 549–564. [Google Scholar] [CrossRef]
- Lite, M.C.; Constantinescu, R.; Tănăsescu, E.C.; Kuncser, A.; Romanițan, C.; Mihaiescu, D.E.; Lacatusu, I.; Badea, N. Phytochemical Synthesis of Silver Nanoparticles and Their Antimicrobial Investigation on Cotton and Wool Textiles. Materials 2023, 16, 3924. [Google Scholar] [CrossRef] [PubMed]
- Asimuddin, M.; Shaik, M.R.; Fathima, N.; Afreen, M.S.; Adil, S.F.; Siddiqui, M.R.H.; Jamil, K.; Khan, M. Study of Antibacterial Properties of Ziziphus Mauritiana Based Green Synthesized Silver Nanoparticles against Various Bacterial Strains. Sustainability 2020, 12, 1484. [Google Scholar] [CrossRef]
- Pawliszak, P.; Malina, D.; Sobczak-Kupiec, A. Rhodiola Rosea Extract Mediated Green Synthesis of Silver Nanoparticles Supported by Nanosilica Carrier. Mater. Chem. Phys. 2019, 234, 390–402. [Google Scholar] [CrossRef]
- Kostić, D.; Velicković, J.; Mitić, S.; Mitić, M.; Randelović, S. Phenolic Content, and Antioxidant and Antimicrobial Activities of Crataegus oxyacantha L. (Rosaceae) Fruit Extract from Southeast Serbia. Trop. J. Pharm. Res. 2012, 11, 117–124. [Google Scholar] [CrossRef]
- Csakvari, A.C.; Moisa, C.; Radu, D.G.; Olariu, L.M.; Lupitu, A.I.; Panda, A.O.; Pop, G.; Chambre, D.; Socoliuc, V.; Copolovici, L.; et al. Green Synthesis, Characterization, and Antibacterial Properties of Silver Nanoparticles Obtained by Using Diverse Varieties of Cannabis sativa Leaf Extracts. Molecules 2021, 26, 4041. [Google Scholar] [CrossRef]
- Gecer, E.N. Green Synthesis of Silver Nanoparticles from Salvia aethiopis L. and Their Antioxidant Activity. J. Inorg. Organomet. Polym. Mater. 2021, 31, 4402–4409. [Google Scholar] [CrossRef]
- Kambale, E.K.; Nkanga, C.I.; Mutonkole, B.-P.I.; Bapolisi, A.M.; Tassa, D.O.; Liesse, J.-M.I.; Krause, R.W.M.; Memvanga, P.B. Green Synthesis of Antimicrobial Silver Nanoparticles Using Aqueous Leaf Extracts from Three Congolese Plant Species (Brillantaisia patula, Crossopteryx febrifuga and Senna siamea). Heliyon 2020, 6, e04493. [Google Scholar] [CrossRef]
- Emam, H.E.; Rehan, M.; Mashaly, H.M.; Ahmed, H.B. Large Scaled Strategy for Natural/Synthetic Fabrics Functionalization via Immediate Assembly of AgNPs. Dye. Pigment. 2016, 133, 173–183. [Google Scholar] [CrossRef]
- Barbinta-Patrascu, M.-E.; Gorshkova, Y.; Ungureanu, C.; Badea, N.; Bokuchava, G.; Lazea-Stoyanova, A.; Bacalum, M.; Zhigunov, A.; Petrovic, S. Characterization and Antitumoral Activity of Biohybrids Based on Turmeric and Silver/Silver Chloride Nanoparticles. Materials 2021, 14, 4726. [Google Scholar] [CrossRef]
- Thepsiri, J.; Audtarat, S.; Dasri, T. Green Synthesis of Silver Nanoparticles Using Ageratum conyzoides for Activated Carbon Compositing to Prepare Antimicrobial Cotton Fabric. Nanotechnol. Rev. 2025, 14, 20250181. [Google Scholar] [CrossRef]
- Usman, O.; Mohsin Baig, M.M.; Ikram, M.; Iqbal, T.; Islam, S.; Syed, W.; Al-Rawi, M.B.A.; Naseem, M. Green Synthesis of Metal Nanoparticles and Study Their Anti-Pathogenic Properties against Pathogens Effect on Plants and Animals. Sci. Rep. 2024, 14, 11354. [Google Scholar] [CrossRef]















| Compound | Molecular Formula | Calculated Mass (m/z) | Measured Mass (m/z) | Mass Accuracy (ppm) | |||
|---|---|---|---|---|---|---|---|
| ESI+ | ESI− | ESI+ | ESI− | ESI+ | ESI− | ||
| Epicatechin | C15H14O6 | 291.086315 | 289.071762 | 291.086179 | 289.071621 | −0.467215 | −0.487768 |
| Quercetin | C15H10O7 | 303.049929 | - | 303.049831 | - | −0.323379 | - |
| Quercetin 3-O-rhamnoside-7-O-glucoside | C27H30O16 | 611.160661 | 609.146108 | 611.1600389 | 609.145543 | −1.017899 | −0.927528 |
| 3-Methylquercetin | C16H12O7 | 317.065579 | - | 317.065498 | - | −0.255468 | - |
| Quercetin-3-D-xyloside | C20H18O11 | - | 433.077635 | - | 433.077572 | - | −0.145470 |
| 5-Desoxyquercetin | C15H10O6 | 287.055014 | - | 287.054990 | - | −0.083608 | - |
| Chlorogenic acid | C16H18O9 | 355.102359 | 353.087806 | 355.102272 | 353.087599 | −0.245000 | −0.586256 |
| 4,5-Dicaffeoylquinic acid | C25H24O12 | 517.134053 | 515.119500 | 517.133259 | 515.119135 | −1.535385 | −0.708573 |
| Vitexin/Apigenin-7-O-glucoside | C21H20O10 | 433.112923 | 431.098370 | 433.112778 | 431.098090 | −0.334786 | −0.649504 |
| 2″-O-α-L-Rhamnopyranosyl-isovitexin | C27H30O14 | 579.170832 | 577.156279 | 579.170522 | 577.155674 | −0.535248 | −1.048243 |
| Isoorientin/Luteolin-7-O-glucoside | C21H20O11 | 449.107838 | 447.093285 | 449.107728 | 447.092835 | −0.244930 | −1.006501 |
| Hyperoside | C21H20O12 | 465.102753 | 463.088200 | 465.102584 | 463.087851 | −0.363361 | −0.753636 |
| Rhoifolin (Apigenin 7-O-neohesperidoside) | C27H30O14 | 579.170832 | - | 579.170618 | - | −0.369494 | - |
| Apigenin 6,8-di-C-glucoside | C27H30O15 | 595.165747 | 593.151194 | 595.165468 | 593.149057 | −0.468777 | −3.602791 |
| 6-Arabinosyl-8-galactosylapigenin | C26H28O14 | 565.155182 | 563.140629 | 565.154995 | 563.140115 | −0.330883 | −0.912738 |
| Isovitexin | C21H20O10 | 433.112923 | - | 433.112951 | - | 0.064648 | - |
| Sample | L* | a* | b* | ∆L* | ∆a* | ∆b* | ∆E* | |
|---|---|---|---|---|---|---|---|---|
| Untreated cotton | 93.48 | −0.27 | 3.83 | - | - | - | - | |
| Untreatedwool | 83.96 | −0.19 | 10.17 | - | - | - | - | |
| AgNPs | Cotton | 88.67 | 0.63 | 3.99 | −4.81 | 0.90 | 0.16 | 4.89 |
| Wool | 79.11 | 0.60 | 8.35 | −4.85 | 0.79 | −1.82 | 5.24 | |
| Bacteria Strain | Textile Sample | CFUs/mL for Reference Samples | CFUs/mL for Samples Treated with AgNP Dispersion | Bacteria Reduction Percentage (%) |
|---|---|---|---|---|
| Escherichia coli | Cotton | 2.1 × 104 | 0 | 99.99 |
| Wool | 2.8 × 104 | 0 | 99.99 | |
| Staphylococcus aureus | Cotton | 4.5 × 104 | 0 | 99.99 |
| Wool | 5.5 × 104 | 0 | 99.99 | |
| Bacillus subtilis | Cotton | 2.9 × 104 | 0 | 99.99 |
| Wool | 3.7 × 104 | 0 | 99.99 |
| Textile Sample | Cotton | Wool |
|---|---|---|
| Microbial Strain | ||
| Escherichia coli | ![]() | ![]() |
| Staphylococcus aureus | ![]() | ![]() |
| Bacillus subtilis | ![]() | ![]() |
| Penicillium hirsutum | ![]() | ![]() |
Disclaimer/Publisher’s Note: The statements, opinions and data contained in all publications are solely those of the individual author(s) and contributor(s) and not of MDPI and/or the editor(s). MDPI and/or the editor(s) disclaim responsibility for any injury to people or property resulting from any ideas, methods, instructions or products referred to in the content. |
© 2025 by the authors. Licensee MDPI, Basel, Switzerland. This article is an open access article distributed under the terms and conditions of the Creative Commons Attribution (CC BY) license (https://creativecommons.org/licenses/by/4.0/).
Share and Cite
Lite, M.C.; Constantinescu, R.; Chirilă, L.; Popescu, A.; Kuncser, A.; Romanițan, C.; Brîncoveanu, O.; Lăcătușu, I.; Badea, N. Antimicrobial Efficacy of Green Silver Nanoparticles Synthesized Using Crataegus monogyna Extract. Biomimetics 2025, 10, 737. https://doi.org/10.3390/biomimetics10110737
Lite MC, Constantinescu R, Chirilă L, Popescu A, Kuncser A, Romanițan C, Brîncoveanu O, Lăcătușu I, Badea N. Antimicrobial Efficacy of Green Silver Nanoparticles Synthesized Using Crataegus monogyna Extract. Biomimetics. 2025; 10(11):737. https://doi.org/10.3390/biomimetics10110737
Chicago/Turabian StyleLite, Mihaela Cristina, Roxana Constantinescu, Laura Chirilă, Alina Popescu, Andrei Kuncser, Cosmin Romanițan, Oana Brîncoveanu, Ioana Lăcătușu, and Nicoleta Badea. 2025. "Antimicrobial Efficacy of Green Silver Nanoparticles Synthesized Using Crataegus monogyna Extract" Biomimetics 10, no. 11: 737. https://doi.org/10.3390/biomimetics10110737
APA StyleLite, M. C., Constantinescu, R., Chirilă, L., Popescu, A., Kuncser, A., Romanițan, C., Brîncoveanu, O., Lăcătușu, I., & Badea, N. (2025). Antimicrobial Efficacy of Green Silver Nanoparticles Synthesized Using Crataegus monogyna Extract. Biomimetics, 10(11), 737. https://doi.org/10.3390/biomimetics10110737